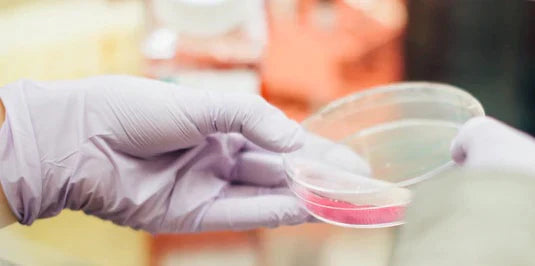

Formula Safe for the Environment
Our consumers care about the environmental impact of the products they buy. And so do we.
That's why we follow a new approach for evaluating ingredient sustainability and their impact on the ecosystem, that is more stringent than required by law. We are committed to use the results to guide ingredient decisions to minimize the negative impact on our planet.
We are working hard to improve all our products, both new and existing. Only those that meet the Highest Standard of Maximizing Biodegradability and Respecting Aquatic Life are awarded with the new icon ‘Formula Safe for the Environment’.

We use stricter criteria which surpass legal requirements
We believe that we need to Do More for our Planet than required by regulations set before us. How do we do that? We use stricter criteria for materials with allowable levels of hazards when choosing ingredients, which surpass legal requirements.
We reduce the incidence and level of Hazard emphasizing AQUATIC SAFETY by prioritizing inert, non-toxic ingredients. When alternatives are not available, we reduce the risk by choosing those that are BIODEGRADABLE to minimize the exposure time within the environment.
Working Together
We have chosen to focus on biodegradability to address exposure and aquatic safety in efforts to minimize hazards, working together these two factors allow us to identify ingredients with lower impact on the environment. A chemical that is less safe to aquatic life may still have a lower impact if the biodegradability is high. It won’t last in water long enough to cause harm. Ensuring materials do not build up in the environment is important.
The SCIENCE behind it
Risk = Hazard x Exposure
Hazard is a measure of the potential of a material to cause harm. Risk is the likelihood of a hazardous material to actually cause that harm. Presence of Hazard is not always accompanied by damage. Take water for example, it‘s an integral part of a plant's growth. But when the exposure is too high, the plant is overwatered and suffers.
Maximizing BIODEGRADABILITY & Respecting AQUATIC LIFE
What happens to the product after I have used it? That depends on two properties: Biodegradability and Aquatic Safety. The combination of these two decides the impact on the environment.
AQUATIC SAFETY refers to the relative safety of aquatic life in the presence of a material. This is the Hazard potential of the material.
BIODEGRADABILITY is the ability of the natural environment to break down a chemical into basic elements so it can blend back in with the earth. This reduces Exposure and minimizes Risk. The resulting basic elements do not harm the aquatic ecosystem which further supports a reduction in presence of hazards.